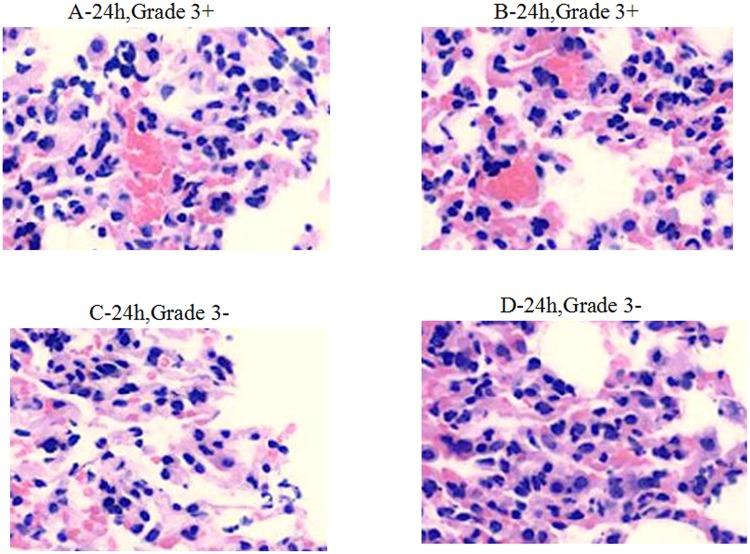
https://cdn.ncbi.nlm.nih.gov/pmc/blobs/4368/4444844/c73eb96c30f1/fmicb-06-00507-g0004.jpg

单独及联合使用抗菌剂对多重耐药鲍曼不动杆菌进行体外和体内分析。
In vitro and in vivo analysis of antimicrobial agents alone and in combination against multi-drug resistant Acinetobacter baumannii.
作者信息
He Songzhe, He Hui, Chen Yi, Chen Yueming, Wang Wei, Yu Daojun
机构信息
The Affiliated First Hospital of Hangzhou, Zhejiang Chinese Medical University Hangzhou, China ; Department of Clinical Laboratories, Hangzhou First People's Hospital Hangzhou, China.
Department of Clinical Laboratories, Hangzhou First People's Hospital Hangzhou, China.
出版信息
Front Microbiol. 2015 May 27;6:507. doi: 10.3389/fmicb.2015.00507. eCollection 2015.
OBJECTIVE
To investigate the in vitro and in vivo antibacterial activities of tigecycline and other 13 common antimicrobial agents, alone or in combination, against multi-drug resistant Acinetobacter baumannii.
METHODS
An in vitro susceptibility test of 101 A. baumannii was used to detect minimal inhibitory concentrations (MICs). A mouse lung infection model of multi-drug resistant A. baumannii, established by the ultrasonic atomization method, was used to define in vivo antimicrobial activities.
RESULTS
Multi-drug resistant A. baumannii showed high sensitivity to tigecycline (98% inhibition), polymyxin B (78.2% inhibition), and minocycline (74.2% inhibition). However, the use of these antimicrobial agents in combination with other antimicrobial agents produced synergistic or additive effects. In vivo data showed that white blood cell (WBC) counts in drug combination groups C (minocycline + amikacin) and D (minocycline + rifampicin) were significantly higher than in groups A (tigecycline) and B (polymyxin B) (P < 0.05), after administration of the drugs 24 h post-infection. Lung tissue inflammation gradually increased in the model group during the first 24 h after ultrasonic atomization infection; vasodilation, congestion with hemorrhage were observed 48 h post infection. After 3 days of anti-infective therapy in groups A, B, C, and D, lung tissue inflammation in each group gradually recovered with clear structures. The mortality rates in drug combination groups(groups C and D) were much lower than in groups A and B.
CONCLUSION
The combination of minocycline with either rifampicin or amikacin is more effective against multi-drug resistant A. baumannii than single-agent tigecycline or polymyxin B. In addition, the mouse lung infection by ultrasonic atomization is a suitable model for drug screening and analysis of infection mechanism.
目的
研究替加环素及其他13种常见抗菌药物单独或联合使用时对多重耐药鲍曼不动杆菌的体外和体内抗菌活性。
方法
采用101株鲍曼不动杆菌进行体外药敏试验,检测最低抑菌浓度(MIC)。通过超声雾化法建立多重耐药鲍曼不动杆菌小鼠肺部感染模型,以确定体内抗菌活性。
结果
多重耐药鲍曼不动杆菌对替加环素(抑制率98%)、多粘菌素B(抑制率78.2%)和米诺环素(抑制率74.2%)表现出高敏感性。然而,这些抗菌药物与其他抗菌药物联合使用产生了协同或相加作用。体内数据显示,感染后24小时给药,联合用药组C(米诺环素+阿米卡星)和D(米诺环素+利福平)的白细胞(WBC)计数显著高于A组(替加环素)和B组(多粘菌素B)(P<0.05)。超声雾化感染后最初24小时内模型组肺组织炎症逐渐加重;感染后48小时观察到血管扩张、充血伴出血。A、B、C、D组抗感染治疗3天后,各组肺组织炎症逐渐恢复,结构清晰。联合用药组(C组和D组)的死亡率远低于A组和B组。
结论
米诺环素与利福平或阿米卡星联合使用对多重耐药鲍曼不动杆菌比单药替加环素或多粘菌素B更有效。此外,超声雾化诱导的小鼠肺部感染是药物筛选及感染机制分析的合适模型。